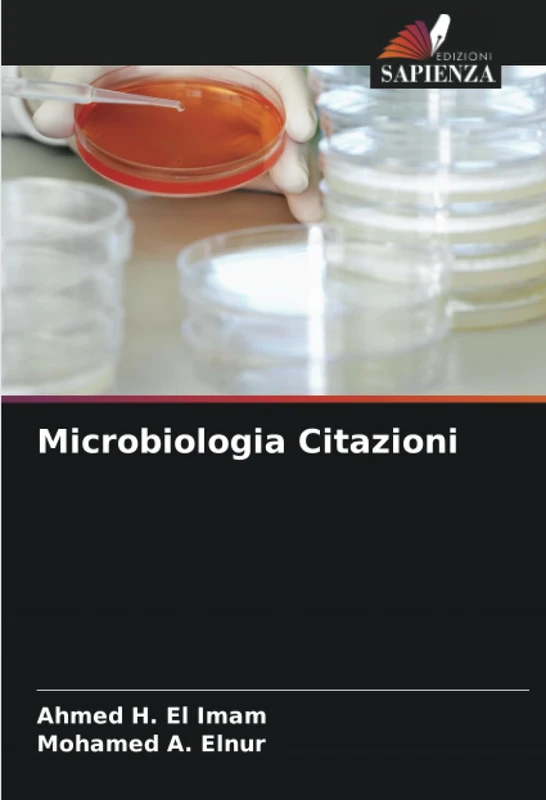
Microbiologia Citazioni
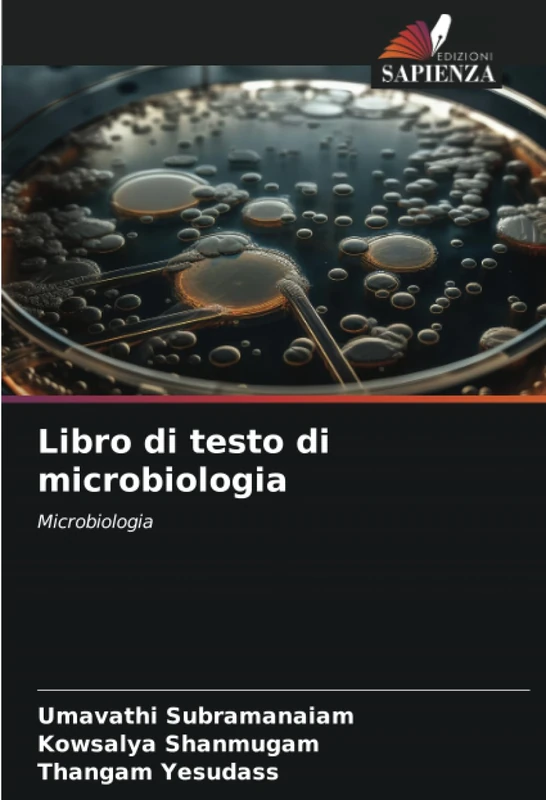
Libro di testo di microbiologia: Microbiologia

We can't find the internet
Attempting to reconnect
Something went wrong!
Hang in there while we get back on track

£71.00
Ecologia microbica: Esplorare l'ecologia oltre l'occhio nudo
Price data last checked 104 day(s) ago - refreshing...
We'll watch every seller, every day. One email when your price arrives.
This is the most expensive it has ever been. Walk away.
£71 today · previous high £71 · all-time low £71
NEW HERE?
Amazon shows you one price. We show you all of them.
Tosheroon watches Amazon prices so you don't have to. Every product on Amazon has a price history — we make it visible. Set the price you'd actually pay, and we'll email you the second it gets there. No app, no account, one email.
WHAT'S ON THIS PAGE
when this has been cheap or pricey
where the price is heading next
all-time high & low, recent range
name your number, we'll email you
Price History & Forecast
Grey patches = out of stock. Cheaper = lower on the chart. Hover for exact prices.
Last 391 days • 391 data points (No recent data available)
Price Distribution
Price distribution over 391 days • 1 price levels
Price Analysis
Most common price: £71 (391 days, 100.0%)
Price range: £71 - £71
Price levels: 1 different prices over 391 days
Product Specifications
- Format
- paperback
- ASIN
- 6208535573
- Domain
- Amazon UK
- Release Date
- 09 January 2025
- Listed Since
- 10 January 2025
Barcode
No barcode data available
Similar Products You Might Like

Regolazione del metabolismo microbico a livello di geni e proteine

Comportamento delle geodetiche e tilings dello spazio iperbolico

Ambienti costruiti sostenibili: dai microclimi alle megalopoli

MICROBIOLOGIA, IMMUNOLOGIA E PATOLOGIA VEGETALE: Tecniche microbiche in biologia

Educare-con-nel-luogo: Recuperare dalla metafisica come tecnicità

Il Bio-Rimediatore: La proliferazione dei nanomateriali e il biorisanamento ambientale

Ecologia, biodiversità e sistematica

Etnofisica: Analisi ellittica di T'nalak

Ecosabidurias: Acqua, Aria, Fuoco e Terra: Conoscenza e autoconoscenza

Il neobarocco nella Bucanera di Alejandra Pizarnik: Un'estetica della molteplicità

Approccio ecologico: Capire ciò che ti circonda
Microbiologia Citazioni

Svelare la minaccia dell'ameba mangia-cervello: Genotipizzazione e sorveglianza

Ecologia della popolazione e dell'habitat Famiglia Ardeidae

MICRO-ENDODONZIA: IL CAMBIAMENTO DI GIOCO NELL'ODONTOIATRIA
Libro di testo di microbiologia: Microbiologia

DISASSUEFAZIONE DELL'ERRONEO: Comportamento cognitivo, sfide e implicazioni sociali

Giambatista Viko o lo spazio di una medialità intermedia

Paradosso della malinconia

Virologia in microbiologia medica malattie virali emergenti e riemergenti

Polimorfismi genici nei microrganismi

Il paradosso di Dio: Disimparare a credere in un mondo razionale

Meditazione profonda: Per l'orientamento della subcoscienza
